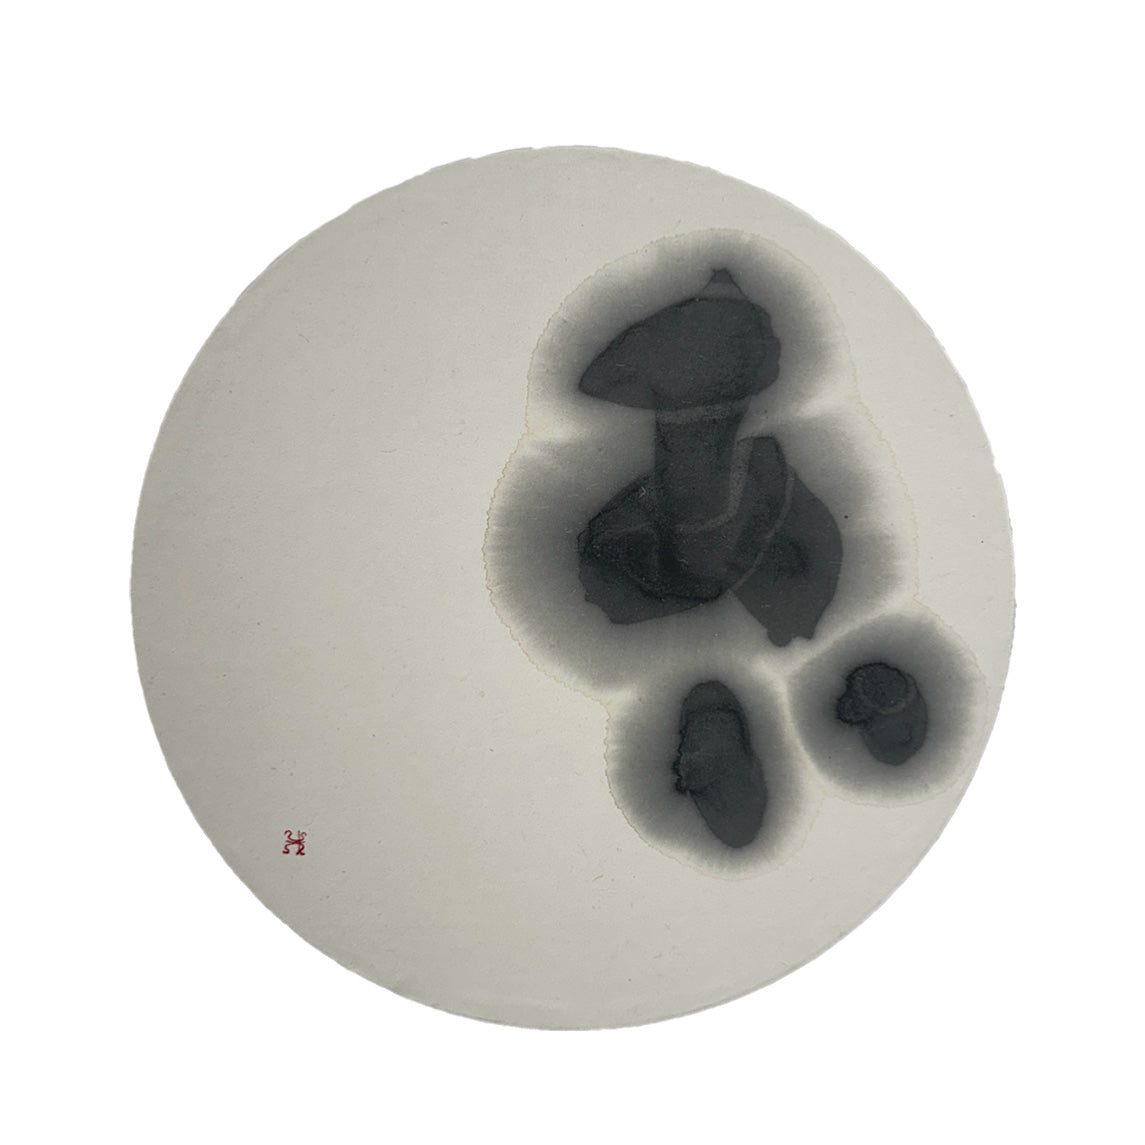

1
の
4
あい
通常価格
¥88,000
セールスプライス
¥88,000
通常価格
セール
完売
税込
【SIZE】H330mm×W330mm×20mm 【WEIGHT】500g 【作品材料】墨、画仙紙 【作品ストーリー】 【作品のポイント】 |
愛情がじわじわと広がっていく。書の滲みを活かしたアイディアの作品です。丸いキャンバスが、そのあいの無限さをも感じさせてくれるようです。